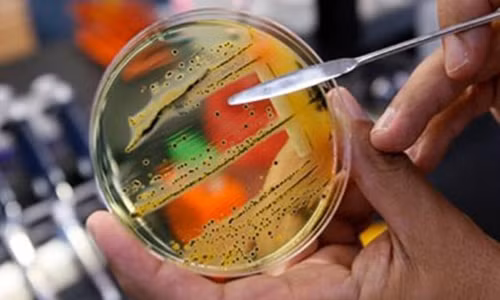
Cai chet cua be 17 ngay tuoi va noi lo cua toan cau

Cái chết ám ảnh
Năm 2010, bé Josiah Cooper-Pope ở Mỹ qua đời khi mới 17 ngày tuổi, khi bị nhiễm trùng trong bệnh viện và không giữ được mạng sống vì không có loại thuốc kháng sinh nào chống được siêu vi khuẩn.
Bé là 1 trong hàng triệu người chết mỗi năm do tình trạng kháng kháng sinh.
Các chuyên gia cảnh báo, càng ngày nấm và ký sinh trùng càng trở nên kháng thuốc.
![]() |
| Mới đây nhất WHO công bố danh sách 12 siêu vi khuẩn đáng lo ngại nhất. |
Trên thực tế, với tình trạng kháng thuốc hiện nay, con người đứng trước nguy cơ mất khả năng điều trị vi khuẩn. Kể từ năm 1987, con người không phát triển thêm một kháng sinh nào trong khi vi khuẩn lại liên tục phát triển và biến đổi.
WHO đã chỉ ra có 12 nhóm vi khuẩn gây ra mối nguy hiểm với sức khoẻ con người, đặc biệt là vi khuẩn đa kháng.
Các nghiên cứu ở Việt Nam cho thấy, các vi khuẩn đường hô hấp kháng Pelicilin là 71%; Kháng erythromycin là trên 92%. Các kháng sinh khác đang kháng thuốc từ 20 -30%, khiến việc điều trị khó hơn.
Ngoài nhóm vi khuẩn gây bệnh hô hấp đã kháng kháng sinh cao, thì vi khuẩn gây tiêu chảy cũng có tỉ lệ kháng cao. Đối với hầu hết các trường hợp, bù nước và điện giải là biện pháp xử trí hiệu quả nhất đối với bệnh tiêu chảy. Chỉ khoảng 1⁄4 số trẻ đã được chỉ định kháng sinh trước khi đưa đến bệnh viện.
Nguyên nhân là tỷ lệ sử dụng kháng sinh ở vùng nông thôn nước ta lên tới 91%, ở thành phố là 88%. Chưa kể đến nguồn kháng sinh trong chăn nuôi.
Khó khăn trong điều trị
PGS.TS Nguyễn Vũ Trung - Phó Giám đốc Bệnh viện Nhiệt đới Trung ương - cho biết, những bệnh nhân mắc vi khuẩn đề kháng thì việc chẩn đoán cũng hết sức khó khăn. Các kháng sinh còn lại để lựa chọn điều trị cũng rất ít.
Trên thế giới, nhiều chủng vi khuẩn gây bệnh đã trở nên ngày càng kháng thuốc kháng sinh. Các kháng sinh “thế hệ một” gần như không được lựa chọn trong nhiều trường hợp. Các kháng sinh thế hệ mới đắt tiền, thậm chí cả một số kháng sinh thuộc nhóm “lựa chọn cuối cùng” cũng đang mất dần hiệu lực.
Bằng chứng mới đây nhất là sự lây lan của chủng vi khuẩn kháng carbapenem (ndm-1) ở một số quốc gia châu Âu và châu Á.
Hiệu lực của kháng sinh nên được xem như một loại hàng hóa đặc biệt, cần được bảo vệ và quí trọng, không nên lãng phí vào các trường hợp không cần thiết.
Ông Cao Hưng Thái - Cục Phó Cục Quản lý khám chữa Bệnh cho biết, tình hình kháng kháng sinh hiện nay không chỉ còn đơn lẻ mà nó trở thành vấn đề toàn cầu và tại Việt Nam cũng tương tự. Ông Thái cho rằng tình trạng kháng kháng sinh ở Việt Nam, ngoài việc người dân tự ý mua thuốc, cũng có nguyên nhân do thầy thuốc.
Nhiều thầy thuốc không ngần ngại khi kê kháng sinh cho bệnh nhân. Với các bệnh nhiễm trùng do vi khuẩn thì kháng sinh còn có tác dụng. Riêng bệnh do vi rút, kháng sinh không có tác dụng điều trị.
Nỗ lực để giảm nhẹ tình trạng kháng kháng sinh, ông Thái hy vọng kiến thức về kháng kháng sinh sẽ được phổ cập trong giáo dục để cộng đồng sử dụng thuốc kháng sinh hợp lý.
Tiếp đến, cần chống lây nhiễm trong bệnh viện và cộng đồng. Hiện Bộ Y tế đã ban hành 700 hướng dẫn chẩn đoán điều trị cho thầy thuốc để sử dụng kháng sinh đúng cách, lập 16 đơn vị giám sát kháng thuốc.